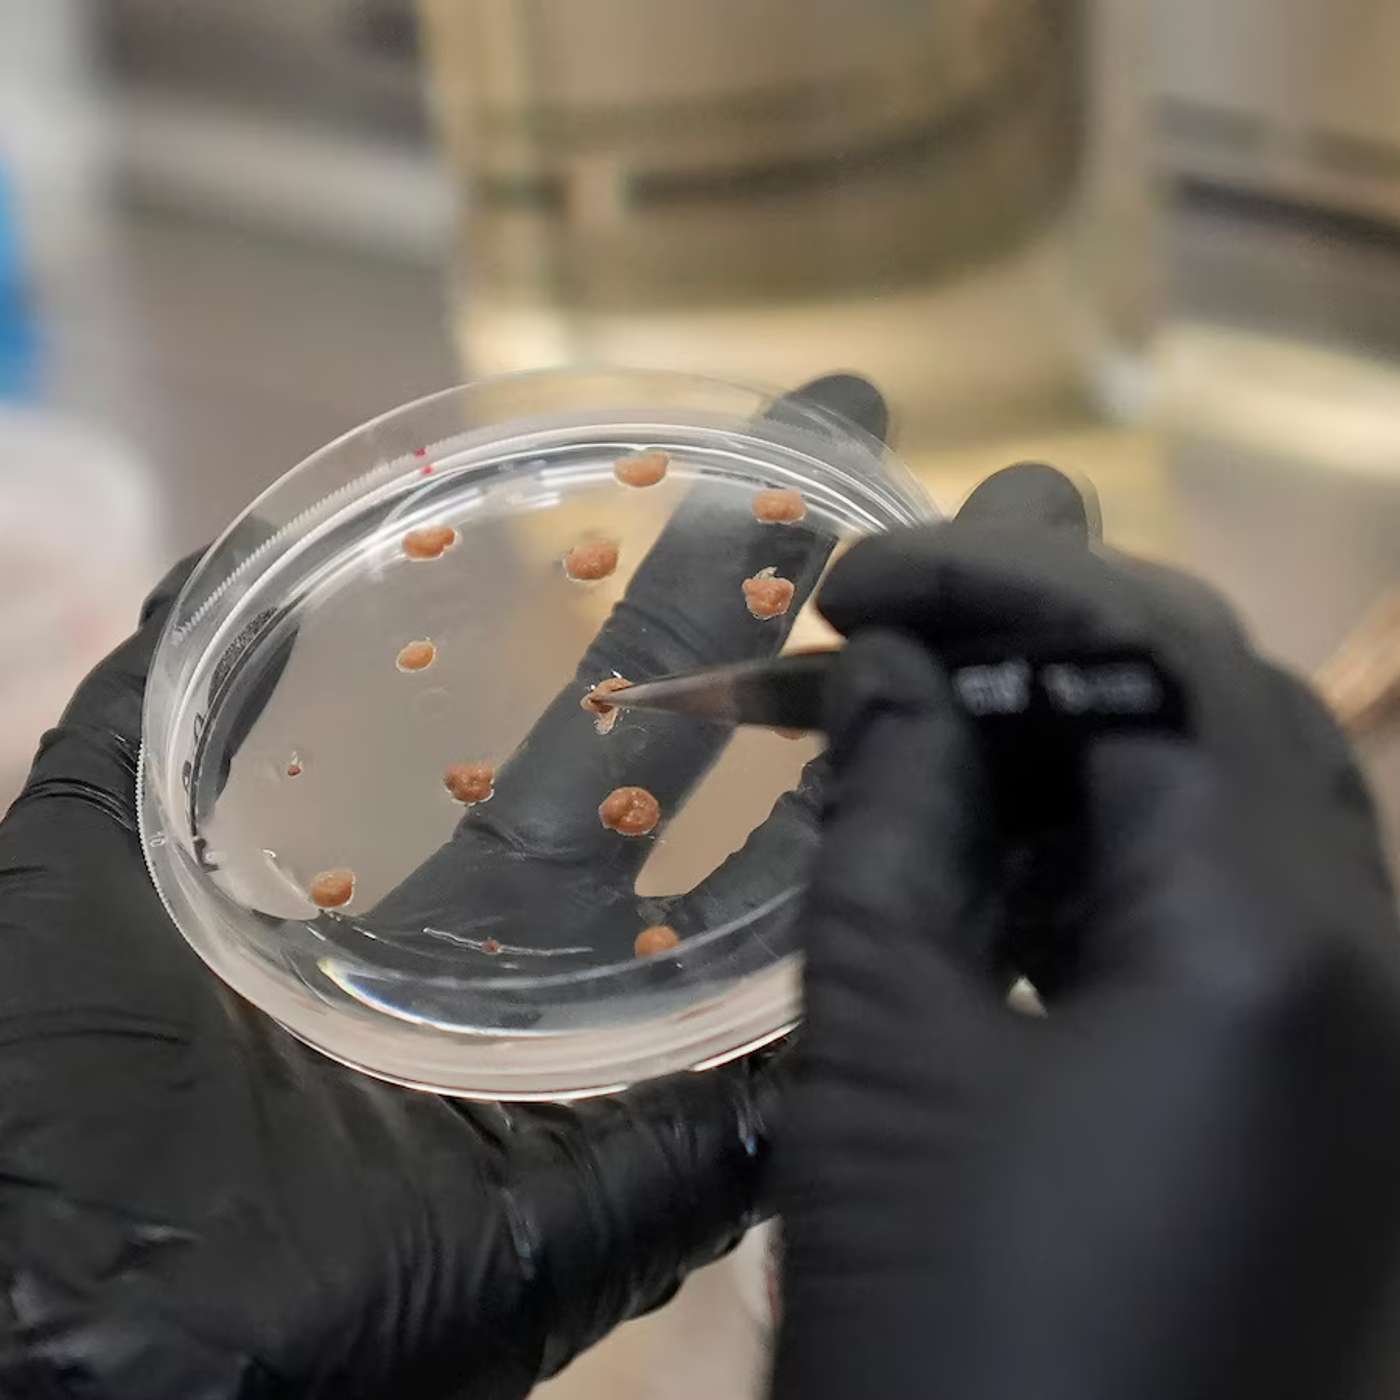
Lab-Grown Cocoa Revolutionizes Chocolate, Advanced Data Techniques Boost Energy Efficiency, RNA Shapes Butterfly Pigments, Trial Shows Risks of Stopping Beta-Blockers, and more...

Podcast Episodes
Back to Search
Liraglutide Reduces BMI in Children, BridgeBio Halts Gene Therapy, Surge in Liver Disorder Cases, Vulcano's Surgery Offers Quick Relief, and more...
(0:10): Breakthrough Study: Liraglutide Significantly Reduces BMI in Young Children, Sparks Debate on Safety and Approval
(2:09): BridgeBio Halts CAH …
1 year, 7 months ago

Cities Face Increased Flood Risks, Study Links Neurons to Infections, Study Unveils OSER1 Protein Benefits, DNA Microbeads Enhance Organoids, and more...
(0:10): Study Reveals Urban 'Wet Islands': Cities Face Increased Rainfall and Flash Flood Risks
(2:03): New Study Links Sensory Neurons to Deadly Hosp…
1 year, 7 months ago

Night Owls Face Diabetes Risk, Ti65 Titanium Alloy Peaks at 600°C, Study Links Insulin Resistance to Diseases, Exercise-Derived Particles Halt Cancer, and more...
(0:10): Night Owls Face Higher Diabetes Risk: New Study Reveals Alarming Health Trends
(2:04): Ti65 Titanium Alloy Shows Peak Strength at 600°C, Faces…
1 year, 7 months ago

Nasal Drops Shorten Kids' Colds, Cats Join Dogs in Fetch, Study Reveals Itch Mechanism, DNA Technique Speeds Evidence Processing, and more...
(0:10): Saline Nasal Drops Cut Kids' Cold Symptoms by 2 Days, Study Finds
(2:35): Study Reveals Cats Love Fetch Too: 40.9% Join Dogs in Playful Behavi…
1 year, 7 months ago

Thorium-229 Revolutionizes Timekeeping, Global Plastic Pollution Crisis Revealed, Breakthrough in Underwater Communication, Study Reveals Hormone Therapy Effects, and more...
(0:10): Breakthrough in Nuclear Clocks: Thorium-229 Achieves Unmatched Precision in Timekeeping
(2:17): Global Study Reveals Shocking Plastic Pollutio…
1 year, 7 months ago

NASA Unveils IceNode Robots, BioVie Gains FDA Approval, M-TEER Procedure Reduces Heart Issues, Bacteria in Plaque Grow Like Forests, and more...
(0:10): NASA Unveils IceNode Robots to Study Antarctica's Melting Ice Shelves and Predict Sea Level Rise
(2:06): BioVie Secures FDA Approval for Long …
1 year, 7 months ago

Titanic Expedition Reveals Decay, Great White Eats Pregnant Shark, Study Reveals Gold Nugget Mechanism, Thailand Fights Invasive Tilapia Crisis, and more...
(0:10): RMS Titanic Expedition Unveils Alarming Decay and Rediscovery of Iconic Bronze Statuette
(2:19): Pregnant Porbeagle Shark Likely Eaten by Grea…
1 year, 7 months ago
Lab-Grown Cocoa Revolutionizes Chocolate, Advanced Data Techniques Boost Energy Efficiency, RNA Shapes Butterfly Pigments, Trial Shows Risks of Stopping Beta-Blockers, and more...
(0:10): California Cultured's Lab-Grown Cocoa Set to Revolutionize Chocolate Industry Amidst Global Supply Challenges
(2:13): Revolutionizing Wind and…
1 year, 7 months ago
Weekend Sleep Reduces Heart Risk, Alfvén Waves Accelerate Solar Wind, Moths Evolve New Activity Patterns, Study Detects Autism Genes, and more...
(0:10): Weekend Catch-Up Sleep Could Lower Heart Disease Risk by 19%, Study Finds
(1:41): Breakthrough Discovery: Alfvén Waves Key to Accelerating and…
1 year, 7 months ago

McGill Study Reveals Dopamine Neurons, Kidney Donation Mortality Rate Drops, Scientists Decode Brain Mechanism, Scientists Warn of Human Extinction, and more...
(0:10): Groundbreaking McGill Study Unveils Key Dopamine Neurons, Paving Way for New Treatments in Brain Disorders
(2:13): Kidney Donation Safer Than …
1 year, 7 months ago